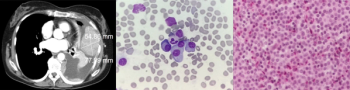
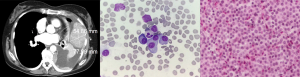

Articles by Kris Mleczko, MD

A 56-year-old Caucasian woman presented to her primary care physician with a 3-month history of intermittent bright red rectal blood with defecation. At her initial visit, a digital rectal examination, anoscopy, and a pelvic examination with DNA testing for high-risk HPV were performed; all results were negative. She was referred for a colonoscopy, which revealed an abnormal area with a 3 × 4–cm mass in the rectum at a distance of 10 cm from the anal verge.

A 57-year-old woman with metastatic HER2/neu-positive breast cancer started treatment with a combination of docetaxel, pertuzumab, and trastuzumab. On the fourth cycle the patient complained of mild irritation and a skin rash on her left upper extremity. What is your diagnosis?
A 70-year-old woman with no history of smoking or asbestos exposure presented with dyspnea on exertion, nonproductive cough, left-sided pleuritic chest pain, and fatigue. Chest radiography revealed a large left pleural effusion and a mass in the left lower lobe. What is the diagnosis?